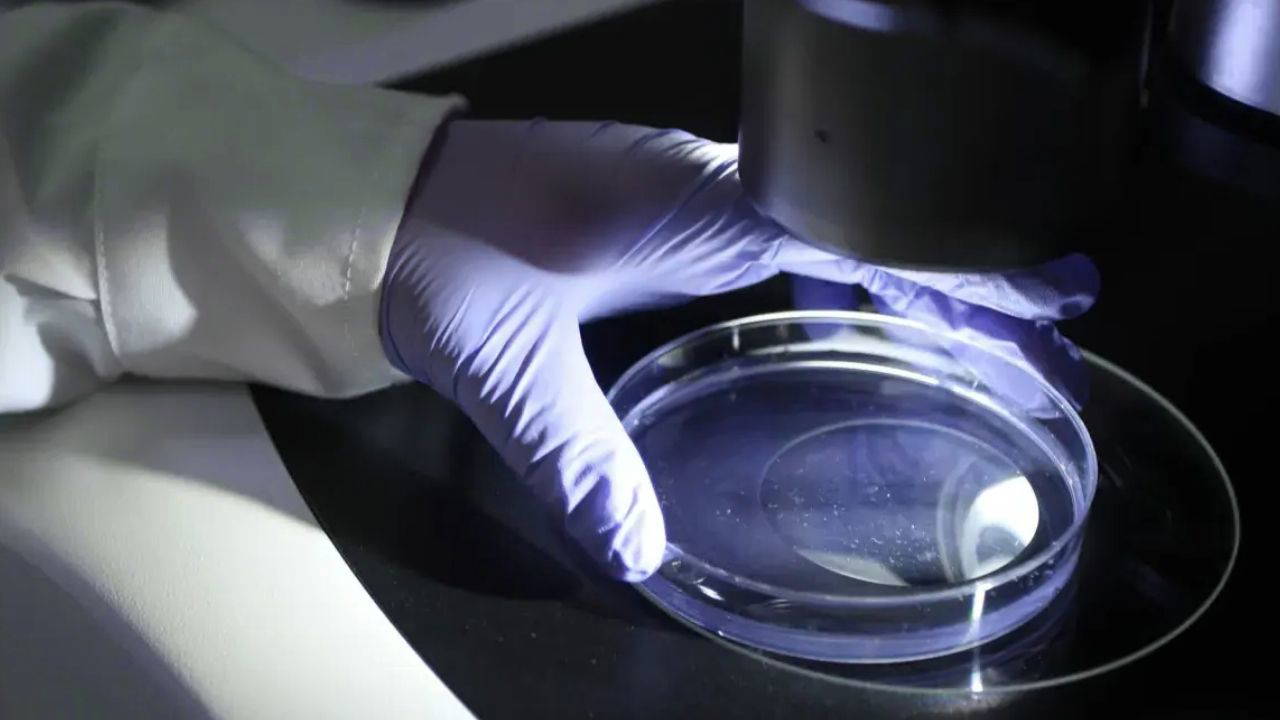

Bilim insanları yapay zekayı kullanarak bakterileri öldürebilen 16 virüs tasarlamayı başardı. Çalışma, antibiyotik tedavilerinde yeni bir döneme işaret ederken biyogüvenlik riskiyle de öne çıktı.
Stanford Üniversitesi ve kar amacı gütmeyen Arc Enstitüsü araştırmacıları yapay zeka yardımıyla 16 işlevsel virüs tasarladı. Bu virüsleri özel kılan şey ise bakterileri etkisiz hale getirebilmeleri. Uzmanlar, bu gelişmeyi sentetik biyoloji alanında önemli bir kilometre taşı olarak değerlendiriyor. Öte yandan hem tedavi potansiyeli hem de olası riskler açısından bilim çevrelerinde tartışmalara yol açıyor.
Donanımhaber’in aktardığına göre araştırmayı yöneten Brian Hie ve ekibi, Evo 1 ve Evo 2 adını verdikleri ileri düzey yapay zeka modellerini kullanarak bakterileri hedef alan virüsler olan bakteriyofajların tam genomlarını tasarladı. Böylece bu çalışma, “tam genomların yapay zeka ile tasarlandığı ilk örnek” olarak kayda geçti.
Araştırmacılar, yapay zeka sistemini yaklaşık 2 milyon bakteriyofaj genomu üzerinde eğiterek virüs DNA dizilerindeki örüntüleri tanımayı öğretti. Ekip, özellikle yalnızca 11 gen ve yaklaşık 5.000 nükleotid içeren basit bir virüs olan phiX174’ün varyantlarını üretmeye odaklandı.

Toplam 302 yapay zeka tasarımı kimyasal olarak sentezlendi ve laboratuvar ortamında test edildi. Bunların 16’sı başarılı olarak E. coli bakterilerini öldürdü ve bazıları doğal virüslerden daha yüksek performans gösterdi.
Ancak bu gelişme bilim camiasında endişe de yarattı. Sentetik DNA ile ilk organizmaları yaratanlardan J. Craig Venter, teknolojinin yanlış kullanılabileceğine dikkat çekerek, “Virüs geliştirmeye odaklanan her türlü araştırmada, özellikle de rastgele ve öngörülemez olanlarda, son derece ihtiyatlı olunmasını şiddetle savunuyorum” dedi.
Araştırmacılar, yapay zekanın eğitim verilerinde insanları enfekte eden virüsleri özellikle dahil etmediklerini belirtse de uzmanlar, bu teknolojinin daha tehlikeli patojenler için kullanılabileceği ve genom tasarım yeteneklerinin yaygınlaşmasının biyogüvenlikrisklerini artırabileceği konusunda uyarıyor.
ANTİBİYOTİKLERİN SONU GELEBİLİR
Öte yandan bu çalışma, antibiyotiklere dirençli enfeksiyonlarla mücadelede önemli bir tedavi potansiyeli sunuyor. Bakteriyofaj terapisi, yani virüsler aracılığıyla zararlı bakterilerin yok edilmesi klasik antibiyotiklerin etkisinin azalmasıyla yeniden ilgi kazanıyor. Uzmanlara göre yapay zeka tarafından tasarlanan virüsler, bakteriyel enfeksiyonlarda geleneksel tedavilere yanıt vermeyen durumlar için yeni bir seçenek olabilir.
AI tarafından tasarlanan çok sayıda faj, laboratuvar ortamında doğal phiX174 virüsünden daha yüksek uygunluk gösterdi ve üretilen virüslerin bir karışımı, üç E. coli suşunda bakteriyel direnci hızla aştı.